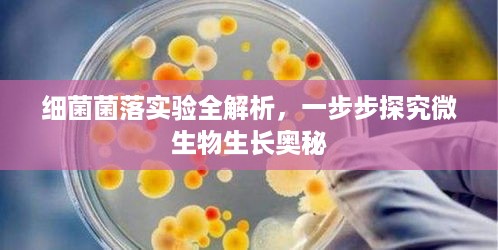

实验目的
通过细菌菌落实验,学习并掌握细菌培养和菌落观察的基本技术,了解细菌的生理特性及环境条件对其生长的影响。
实验原理
细菌菌落实验是通过将细菌接种在固体培养基上,观察其生长过程及菌落特征,从而了解细菌的生长规律、形态特征和生理特性,细菌在固体培养基上形成菌落,其大小、形状、颜色等特征可反映细菌的种类和生理特性。
实验步骤
1、准备器材与试剂:培养基、培养皿、接种环、酒精灯、棉签、无菌水等。
2、配制培养基:按照实验要求,选择合适的培养基进行配制。
3、高压蒸汽灭菌:对培养基和培养皿进行高压蒸汽灭菌,以确保无菌环境。
4、细菌接种:用棉签蘸取少量细菌样本,在无菌操作台上轻轻涂抹于培养皿中的培养基上。
5、培养条件设置:将接种好的培养皿置于恒温培养箱中,设置合适的温度和时间。
6、菌落观察与记录:定期观察菌落生长情况,记录菌落的大小、形状、颜色等特征。
7、结果分析:根据实验结果,分析细菌的生理特性和环境条件对其生长的影响。
实验注意事项
1、操作过程中要保持无菌环境,避免污染。
2、接种时要轻轻涂抹,避免过于用力导致细菌扩散。
3、培养条件要适宜,温度、湿度等要控制好。
4、菌落观察时要定期记录,避免遗漏重要信息。
实验结果与分析
通过实验,我们观察到了不同细菌在不同条件下的菌落特征,记录了菌落的大小、形状、颜色等特征,通过对实验结果的分析,我们可以了解不同细菌的生理特性和环境条件对其生长的影响,某些细菌在富含营养的培养基上生长迅速,形成较大的菌落;而某些细菌在贫瘠的培养基上也能生长,表现出较强的生存能力,温度、湿度等环境条件也会影响细菌的生长和菌落特征。
通过细菌菌落实验,我们学习并掌握了对细菌培养和菌落观察的基本技术,实验结果表明,不同细菌具有不同的生理特性和环境条件适应性,通过观察和分析菌落特征,我们可以初步判断细菌的种类和生理特性,为进一步研究细菌的生物学特性提供重要依据。
实验建议与拓展
1、在实验过程中,可以尝试使用不同类型的培养基,以观察不同细菌对不同营养条件的适应性。
2、可以尝试改变培养条件,如温度、湿度等,以观察环境条件对细菌生长的影响。
3、可以进一步探索细菌的生理特性,如耐药性、生物膜形成等,以更全面地了解细菌的生物学特性。
4、可以将实验结果与临床实际相结合,探讨细菌菌落实验在疾病诊断和治疗中的应用价值。
通过本次实验,我们对细菌的生长规律、形态特征和生理特性有了更深入的了解,这将有助于我们在未来的学习和工作中更好地应用细菌菌落实验,为细菌学研究做出贡献。
转载请注明来自无忧安证,本文标题:《细菌菌落实验全解析,一步步探究微生物生长奥秘》

蜀ICP备2022005971号-1
蜀ICP备2022005971号-1
还没有评论,来说两句吧...